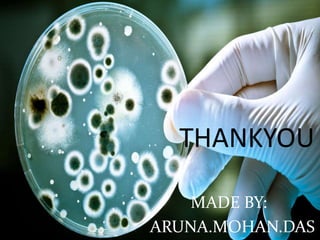
THANKYOU 
MADE BY: 
ARUNA.MOHAN.DAS

Professor Patricia Jevons discovered methicillin-resistant Staphylococcus aureus (MRSA) in 1961, following the introduction of methicillin as a treatment for penicillin-resistant staph infections. MRSA is a strain of staph bacteria resistant to several antibiotics, making infections difficult to treat and potentially life-threatening. With evolving antibiotic resistance and the emergence of new resistant strains, MRSA presents ongoing challenges for public health and the medical community.